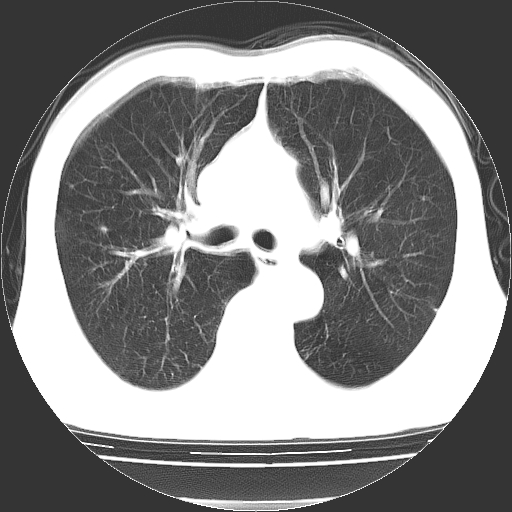
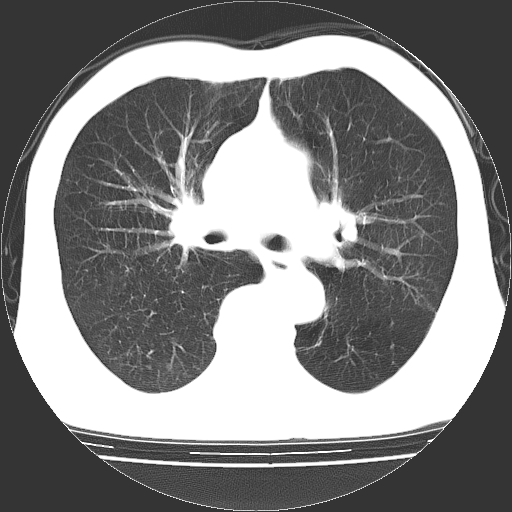
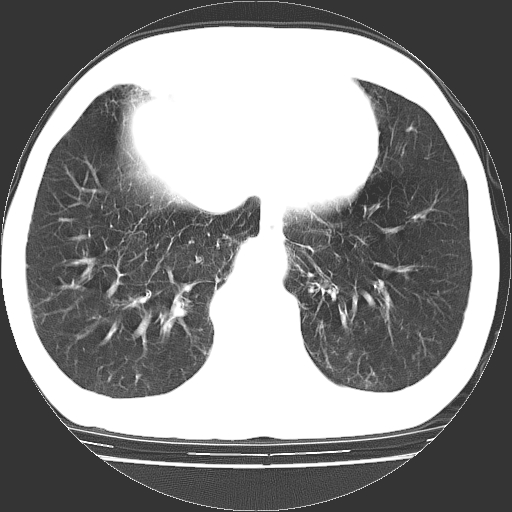

以下是引用hhcckk在2009-1-1 15:38:00的发言:[br]左下肺少许絮状模糊影--考虑感染[br]两肺散在小点状密度增高影--结合病史考虑矽肺?[br]气管壁钙化--可能由于老年退变性引起的
以下是引用hhcckk在2009-1-1 15:38:00的发言:[br]左下肺少许絮状模糊影--考虑感染[br]两肺散在小点状密度增高影--结合病史考虑矽肺?[br]气管壁钙化--可能由于老年退变性引起的
以下是引用hhcckk在2009-1-1 15:38:00的发言:[br]左下肺少许絮状模糊影--考虑感染[br]两肺散在小点状密度增高影--结合病史考虑矽肺?[br]气管壁钙化--可能由于老年退变性引起的
以下是引用hhcckk在2009-1-1 15:38:00的发言:[br]左下肺少许絮状模糊影--考虑感染[br]两肺散在小点状密度增高影--结合病史考虑矽肺?[br]气管壁钙化--可能由于老年退变性引起的
以下是引用hhcckk在2009-1-1 15:38:00的发言:[br]左下肺少许絮状模糊影--考虑感染[br]两肺散在小点状密度增高影--结合病史考虑矽肺?[br]气管壁钙化--可能由于老年退变性引起的
| 欢迎光临 医影在线 (http://bbs.radida.com/bbs/) | Powered by Discuz! X3.2 |